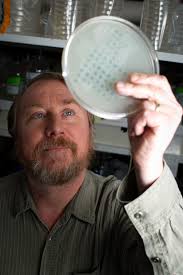

לסא"ל יהונתן צור, מפקד גדוד הסיור של הנח"ל שנפל ב 7.10 כולם קראו "ברנש" במלעיל, קיצור של ברנשטיין, שם משפחתו המקורי. הוא הותיר אחריו אשה עם השם היפה ראשית ושלושה ילדים. בגינה שלהם יש חיפושית כחולה ישנה. ראשית סיפרה ל"ישראל היום" שעם המכונית הזו הוא ניסה להסביר לי למה שווה לה לצאת




איתו. ברנש אמר לה 'אני בשלדג, יש לי אופנוע ויש לי חיפושית'. שלדג לא הרשים אותה, גם לא האופנוע, אבל מול החיפושית כבר היא לא יכלה להישאר אדישה. הם חרשו את הארץ, והיו לה אינסוף תקלות. בין השאר, בכל פעם שלחצו על הבלם גם הצופר עבד. כל תאונה או עצירה היו מלוות ברעש מחריש אוזניים של
הצופר הסורר ובמבטים המומים של עוברים ושבים.
היה לו לברנש סיפור חיים מעניין. הוא הפך מנער גבעות עם תיקים פליליים לקצין מוערך. בדרך גם הסיר את הכיפה. אמנע מלהכניס כאן פוליטיקה.
בשנים האחרונות הוא איבד בלחימה את סגנו בר פלח ובצוק איתן את חברו בניה שראל.
יהי זכרו ברוך.
היה לו לברנש סיפור חיים מעניין. הוא הפך מנער גבעות עם תיקים פליליים לקצין מוערך. בדרך גם הסיר את הכיפה. אמנע מלהכניס כאן פוליטיקה.
בשנים האחרונות הוא איבד בלחימה את סגנו בר פלח ובצוק איתן את חברו בניה שראל.
יהי זכרו ברוך.

אחותו צרויה: "אחי הגדול והטוב, יהונתן.
'איך נפלו גיבורים ויאבדו כלי מלחמה', איזו אבידה לכל העם, לצבא ולחיילים שהעריצו אותך. סגן אלוף, מפקד הסיירת, ברנש - זה מה שהיית בעולם שבחוץ.
בשבילנו היית פשוט יהונתן. האח הבכור, המצחיק, השטותניק, זה שרואה מטרה ולא מרפה ממנה, מסמר הערב בכל
'איך נפלו גיבורים ויאבדו כלי מלחמה', איזו אבידה לכל העם, לצבא ולחיילים שהעריצו אותך. סגן אלוף, מפקד הסיירת, ברנש - זה מה שהיית בעולם שבחוץ.
בשבילנו היית פשוט יהונתן. האח הבכור, המצחיק, השטותניק, זה שרואה מטרה ולא מרפה ממנה, מסמר הערב בכל
מקום. האח שדאג לכולנו בזמנים טובים וטובים פחות, שידע ליהנות מהחיים, לטייל, לאכול טוב ולתת לכולנו הרגשה של בית. האח שמת כמו שחי, ללא פחד ובלי להסתכל אחורה.
צר לי עליך אחי יהונתן. מקווה שאתה שם למעלה הופך עולמות ודואג לעם ולארץ שכל כך אהבת, מתפלל בשבילנו לניצחון גדול שייראה
צר לי עליך אחי יהונתן. מקווה שאתה שם למעלה הופך עולמות ודואג לעם ולארץ שכל כך אהבת, מתפלל בשבילנו לניצחון גדול שייראה
בכל העולם, ולקידוש ה' שלא נראה כמוהו. אוהבת, צרויה אחותך."
• • •
Missing some Tweet in this thread? You can try to
force a refresh

 Read on Twitter
Read on Twitter